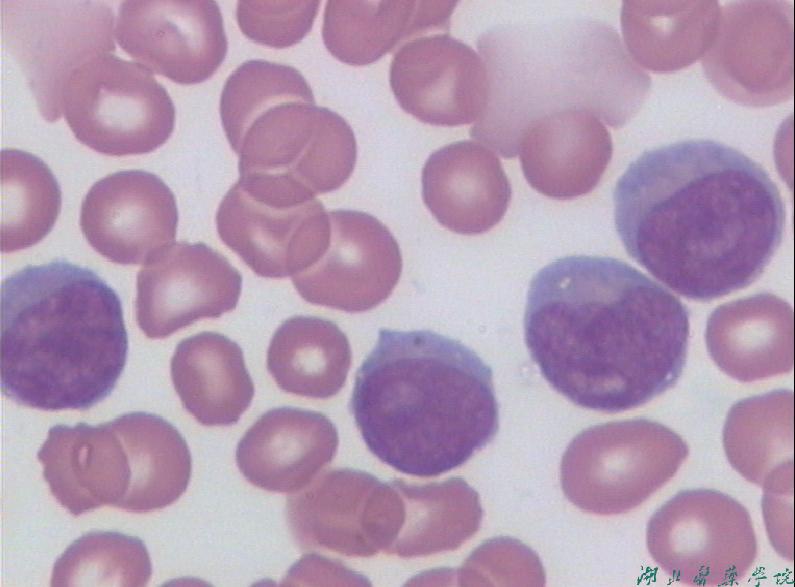

#患者姓名:曹**
#性别:女
#年龄:48岁
#主诉:发现血象异常1天。
#现病史:患者1天前因“腹胀、双下肢水肿”于当地医院住院治疗,住院期间查血常规提示:WBC 77.53G/L,PLT 56G/L,病程中无头晕、乏力、心悸,无畏寒、发热,无咳嗽、咳痰,无腹痛、腹泻,无尿频、尿急、尿痛,无牙龈出血、鼻出血等不适,当地医院考虑白血病可能,建议转上级医院进一步诊治,急诊以"白细胞升高待查:白血病?"收入院。起病以来,患者精神、睡眠尚可,食欲欠佳,大便正常,小便量少,体力、体重无明显变化。
#既往史:有类风湿性关节炎病史20余年,目前全身多处关节僵硬畸形、活动受限,近1年服用雷公藤治疗。1年前于当地医院诊断左侧股骨头缺血坏死。有慢性胃炎病史多年。
#个人史:生于当地,久居当地。否认疫区、疫水接触史。否认毒物,放射性物质接触史。否认烟酒嗜好。
#家族史:无。
#专科检查:T37.1℃,P78bpm,R22bpm,BP 137/87mmHg。发育正常,营养中等,神志清楚,右侧腹壁皮肤有红色皮疹分布 ,双侧颈部、腋窝、腹股沟均可扪及多枚肿大淋巴结,最大约2*3cm大小,位于右侧腋窝,质地中等,边界清楚,表面光滑,无触压痛,表面皮肤无红肿、破溃。颈软,甲状腺不大。两肺呼吸音清,未闻及干湿啰音。心律齐,未闻及病理性杂音。有胸骨叩痛,腹平软,无压痛、反跳痛,肝区叩痛,Murphy阴性,肝:右肋下未扪及?,胆囊:未触及,胆囊区无压痛,Murphy征阴性,脾脏:左肋下2cm。双下肢重度凹陷性水肿。四肢小关节可见明显畸形,膝关节、髋关节、肘关节僵硬,活动受限。生理反射存在,病理反射未引出,克氏征、布氏征阴性
#辅助检查结果:
血常规:
2018-5-18在外院查血分析示:WBC 77.53×10^9/L,NE10.8 %,NE 8.38×10^9/L,LY 88.5%,LY 68.54×10^9/L,RBC 4.22×10^12/L,HGB 116 g/L,PLT 56×10^9/L。肝功能:ALT 106U/L,AST 181U/L,TP 61.2g/L。
5-19我科查血液分析:WBC 88.74×10^9/L,NE 10.36%,NE 13.3×10^9/L,LY 85.8%,LY 66.65×10^9/L,RBC 4.13×10^12/L,HGB 114g/L,PLT 42 ×10^9/L。
外周血白细胞分类:杆状核3%,分叶核5%,淋巴细胞89%,单核细胞3%,红细胞未见明显异常,血小板散在可见,部分淋巴细胞可见毛状突起。
淋巴细胞亚群分析:
外周血淋巴细胞亚群示T细胞(CD3+CD56-)占93.85 % ↑,比例明显增高,B细胞(CD3-CD19+)占0.67 % ↓,NK细胞(CD3-CD56+)占0.2 % ↓,NK/T细胞(CD3+CD56+)占0.15 % ,辅助性T细胞(CD3+CD4+)占0.6 % ↓参考值:41.6-60.1 %,抑制性T细胞(CD3+CD8+)占92.22 % ↑,参考值17.8-30.4
CD4+/CD8+=0.01 ↓参考值1.27-3.06。
影像学检查
CD8+的T淋巴细胞增殖性肿瘤?
肝胆脾彩超:肝脏肿大并弥漫性病变胆囊壁明显水肿脾肿大。
双肾、输尿管、膀胱未见明显异常。
心电图:1、窦性心律2、正常心电图。
骨髓流式


淋巴细胞群约占全部有核细胞的56.33%,比例偏高,表达CD7、CD3、CD2、CD5,少部分表达CD13、HLA-DR,不表达CD117、CD34、CD25、CD30、CD15、CD16、CD56、CD57。
分析CD3+细胞群约占全部有核细胞的40.17%,表达CD7、CD2、CD5,少部分表达TCRαβ,不表达TCRγδ、CD57、CD103、cTdT、cCD79a、cCD3,CD3+CD4+CD8-/CD3+CD4-CD8+=0.26,其中CD3+CD4-CD8-细胞约占淋巴细胞群的83.38%,比例增高。
结论:CD4-/CD8-T淋巴细胞约占全部有核细胞的46.96%,比例偏高。
骨髓细胞学检查
骨髓增生明显活跃,幼稚淋巴细胞占54.5%,符合幼稚淋巴细胞白血病。

骨髓病理:符合幼淋巴细胞白血病。

骨髓染色体:
核型:45,XX,+ider(3)(p10)inv(3)(q21p26),der(8)dup(8)(q10),+19,-21,-22,-22[27]
结果解释:T幼淋巴细胞白血病患者骨髓标本,经72h培养后,共分析27个中期分裂相,均为复杂幼稚核型,结构性异常包括ider(3),inv(3),dup(8),数目异常包括+19,-21,-22,请结合临床及相关检测结果综合评估预后。

#诊断:幼淋巴细胞白血病(PLL)
#治疗:目前,首选的治疗方案仍然是阿仑单抗进行诱导治疗,随之在符合条件的患者中予异基因造血干细胞移植巩固使患者获得长期疾病控制。对于不符合移植条件的患者,在阿仑单抗诱导后尚不推荐进行异基因造血干细胞移植巩固。
#总结与思考:
PLL是一种特殊类型的淋巴细胞白血病,一般认为属罕见的慢淋变异,但也有人认为是急淋的一种亚型。发病率在慢性淋巴细胞增殖性疾病中<2%。根据细胞来源可分为B-PLL和T-PLL。
PLL病程较CLL短,好发于60岁以上老年人,男性居多,男女之比约为4:1,临床特点为起病缓,可无明显的自觉症状,部分病例可因消瘦,纳差,盗汗,乏力及上腹部不适而就诊,其主要特征是白细胞异常升高,外周血中幼淋巴细胞占55%以上及脾大。
血象:70%患者有贫血和血小板减少,属于正细胞性贫血,白细胞总数明显增高也可正常,多数>100×109/L,以幼淋巴细胞占优势,55%以上。
骨髓象:增生明显活跃,有核仁的幼淋巴细胞占17%-80%,其他系增生受抑。
细胞化学染色:部分幼淋巴细胞PAS+,ACP+,但TRAP阴性,T-PLL的ANEA为强阳性。
免疫表型:B-PLL高表达IgM,CD19+,CD20+,CD22+,HLA-DR+,FMC-7+,CD103-,CD11c-,CD5+/-,CD10-。T-PLL有25%的患者共表达CD4/CD8,是T-PLL的独特特点,其表型为CD2+,CD3+,CD7+,60%患者表达CD4+/CD8-,15%患者CD4-CD8+。CD52强阳性表达,可作为治疗靶点。克隆分析示有TCR受体基因重排。
细胞遗传学和分子生物学:T-PLL特征性的细胞遗传学异常为14号染色体倒位[inv(14)(qllq23)]和t(14;14)(q1lq23),可见于70%的患者,t(x;14)(q28q11)可见于20%的患者,8号染色体异常(8号染色体3体,等臂染色体8 q)为仅次于前述的常见异常。
